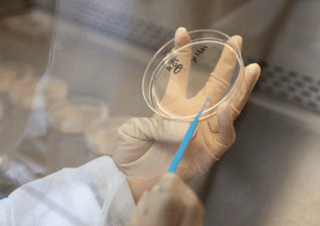

Une première en France : Le CRCT – Centre de Recherche Clinique et Translationnelle, centre de recherche pour accélérer le progrès médical situé à l’interface entre recherche exploratoire et clinique, vient d’être inauguré ce mardi 3 mars 2015. Il est destiné à créer un continuum recherche-soins en rassemblant chercheurs, industriels et praticiens hospitaliers et leur offrir les conditions pour franchir les étapes du développement des innovations biomédicales jusqu’à l’application clinique. Objectif : favoriser le passage des nouvelles thérapies des laboratoires vers la pratique médicale et accélérer ainsi le progrès médical. Pour que chercheurs et médecins travaillent ensemble.
Bâti au cœur du Genopole d’Evry et à proximité du Centre Hospitalier Sud Francilien (CHSF), le Centre de Recherche Clinique et Translationnelle (CRCT) sud-francilien, dont la première pierre avait été posée le 12 septembre 2013 et qui a ouvert ses portes à l’automne 2014, a été inauguré mardi 3 mars par Isabelle This Saint-Jean, présidente de Genopole et vice-présidente du Conseil régional d’Ile-de-France en charge de l’enseignement supérieur et de la recherche, Jérôme Guedj, président du Conseil général de l’Essonne, Jean-Pierre Bechter, président de la Communauté d’agglomération Seine Essonne et maire de Corbeil-Essonnes et Pierre Tambourin, président du CRCT.
La plaque inaugurale a été dévoilée après une visite du bâtiment, de ses laboratoires de confinement L1 et L2, ses espaces communs et espaces techniques et du plateau qui sera aménagé ultérieurement pour accueillir une plateforme dédiée aux cellules souches.
 « Ce centre constitue une première en France, un centre entièrement dédié à la recherche dite ‘translationnelle’ » souligne Pierre Tambourin, Directeur Général de Genopole, et vice-président de Medicen Paris Région.
« Ce centre constitue une première en France, un centre entièrement dédié à la recherche dite ‘translationnelle’ » souligne Pierre Tambourin, Directeur Général de Genopole, et vice-président de Medicen Paris Région.
La recherche translationnelle est née récemment du constat de la difficulté de réaliser ou de poursuivre des recherches importantes pour les malades. Elle vise à tisser un lien efficace entre les différentes formes de recherche, fondamentale, finalisée, appliquée et clinique, avec l’objectif que les progrès des connaissances se concrétisent au plus vite en avancées médicales pour le patient, en regrouper et faisant coopérer des spécialistes de toutes les étapes du processus – de l’éprouvette au lit d’hôpital – et en veillant à ce que l’information circule dans les deux sens : du fondamental vers l’appliqué et de l’appliqué au fondamental, pour créer une véritable synergie.
Le CRCT, nouveau modèle d’organisation de la recherche, est conçu comme un hôtel à projets, destiné à accueillir des projets ponctuels de recherche translationnelle. Pierre Tambourin précise : « Nous ne louerons pas que des murs, mais tout un environnement. Nous mettrons en place un réseau de compétences autour de ce centre et nous apporterons aussi l’environnement scientifique qui servira d’appui à ces projets. C’est dans cet esprit que l’Institut des cellules souches I-Stem, unité Inserm/AFM-Téléthon très impliquée en recherche translationnelle, sera prochainement installé dans ce bâtiment. »
Une structure d’interface pour valoriser le potentiel scientifique, industriel et hospitalier d’Evry-Corbeil et voir émerger des thérapies innovantes
Quatre axes de recherches prioritaires sont réunies dans la structure : « les nouvelles approches thérapeutiques », la « génomique », la « visualisation du vivant » et les « investigations épidémiologiques, cliniques et thérapeutiques ». Ce centre est appelé à devenir l’un des principaux acteurs du pôle de compétitivité Medicen Paris Région.
– Le CRCT sud-francilien est bâti au cœur de Genopole, à proximité immédiate du Centre Hospitalier Sud Francilien (CHSF) et de l’AFM-Téléthon. Il bénéficie de l’environnement propice du biocluster, scientifique, universitaire et industriel, et apporte la structure pour que soit établi le lien entre l’hôpital, les laboratoires et les entreprises.
– Le biocluster Genopole réunit des laboratoires académiques de recherche, des entreprises de biotechnologies et des plates-formes technologiques mutualisées. Il ambitionne de construire la médecine de demain. Au gré des progrès de la génomique et des biotechnologies, de nouvelles thérapies y sont mises au point.
– L’AFM-Téléthon est un acteur majeur de la recherche biomédicale pour les maladies rares. Ses laboratoires Généthon et I-Stem, présents sur le site, sont des leaders en thérapie génique et thérapie cellulaire. Généthon Bioprod est le plus grand centre de production de médicaments de thérapie génique au monde.
– Le CHSF, établissement de référence pour le sud de l’Ile-de-France, représentant un bassin de population de 600 000 habitants, compte plus de 1 000 lits et dispose d’une plate-forme de recherche clinique depuis son ouverture en 2012. Le CRCT viendra consolider l’implication dans la recherche des équipes médicales du CHSF. L’accord de coopération conclu entre le CHSF et les hôpitaux universitaires Paris-Sud ouvre des perspectives communes en matière de recherche.
– L’Université d’Evry-Val-d’Essonne (UEVE), avec ses 18 laboratoires, constitue un pôle majeur de la recherche sud-francilienne. Université pluridisciplinaire et professionnalisante, l’UEVE est reconnue pour la diversité de son offre de formation et pour la qualité de sa recherche et son excellence dans le domaine de la génomique et de la post-génomique appliquées à la santé et à l’industrie.
Par ailleurs, le CRCT souhaite développer des partenariats avec des établissements hospitalo-universitaires. Le maillage de collaborations entre les praticiens hospitaliers et les équipes de recherche sera impulsé par la nature des innovations.
Un hôtel à projets
Concept novateur d’une infrastructure de recherche mutualisée, le CRCT est destiné à accueillir et accompagner des projets de transfert d’une technologie ou de conduite d’un prototype ou d’un produit vers l’hôpital pour des périodes temporaires de quelques mois à deux ans. Il offre 700 m² de laboratoires privatifs ou semi-privatifs de confinement L1 et L2, 550 m² de bureaux et 350 m² d’espaces communs, livrés clés en main, ainsi qu’une salle de conférence d’une capacité de 150 personnes.
Concept novateur d’une infrastructure de recherche mutualisée, le CRCT est destiné à accueillir et accompagner des projets de transfert d’une technologie ou de conduite d’un prototype ou d’un produit vers l’hôpital pour des périodes temporaires de quelques mois à deux ans. Il offre 700 m² de laboratoires privatifs ou semi-privatifs de confinement L1 et L2, 550 m² de bureaux et 350 m² d’espaces communs, livrés clés en main, ainsi qu’une salle de conférence d’une capacité de 150 personnes.
Un accueil “guichet unique” devrait faciliter la mise en relation avec les cliniciens du CHSF et la contractualisation avec l’hôpital, et apporter une expertise administrative et juridique.
Deux projets I-Stem de recherche translationnelle au CRCT :
• PACE, réalisé en collaboration étroite avec l’AP/HP (Hôpital Tenon) qui en assure la promotion, est destiné à évaluer le potentiel de greffes d’épiderme dérivé de cellules souches embryonnaires pour le traitement d’ulcères cutanés associés à la drépanocytose.
• STREAM, mené en collaboration étroite avec l’Institut de la Vision, vise à évaluer le potentiel de greffes d’épithélium pigmentaire rétinien produit à partir de cellules souches embryonnaires et secondairement de cellules induites à la pluripotence pour le traitement de rétinites pigmentaires d’origine génétique et de la DMLA atrophique.
Valoriser la recherche sur les cellules souches
L’activité du CRCT démarre autour de la thérapie cellulaire, avec l’installation de l’Institut des cellules souches I-Stem, plus grand laboratoire de R&D français dédié aux cellules souches pluripotentes humaines. Pour son directeur scientifique Marc Peschanski : “Le CRCT est un outil extraordinaire pour nous permettre d’aller plus vite au malade, à l’essai clinique et, dès que les résultats l’autoriseront, à la mise à disposition de thérapies innovantes”
Cette première collaboration permettra au CRCT de faire sa preuve de concept sur des programmes importants de recherche translationnelle visant l’application de cellules souches à des fins thérapeutiques.
Le CRCT profitera aussi des opportunités de mutualisation de moyens et ressources avec I-Stem pour développer une expertise scientifique et clinique dans le domaine des biothérapies, et étendre ses offres technologiques en proposant notamment l’accès à des plates-formes robotiques de haut niveau pour la production cellulaire en masse et le criblage à haut et moyen débits de composés à potentiel thérapeutique.
« Pôle d’excellence en matière de recherche, j’espère que le CRCT sera aussi un pôle d’excellence en matière d’application médicale » déclare Jean-Pierre Bechter.
Jérôme Guedj quant à lui, estime qu’ils ont à Evry-Corbeil « un pôle de visibilité internationale en santé, génomique et biotech. Les deux centres récemment construits, CRCT et Généthon Bioprod, sont deux projets cohérents qui illustrent la réussite du Département « . Propos confirmés par Isabelle This Saint-Jean : « Nous sommes ici sur un site très particulier qui regroupe formation, innovation et médecine. Il n’est donc pas étonnant que ce centre original y soit installé. Il illustre une dynamique forte, tournée vers l’avenir « .
Le CRCT concrétise là un partenariat réussi entre Genopole, le Centre Hospitalier Sud Francilien, l’AFM-Téléthon et l’Université d’Evry-Val-d’Essonne.
Le projet a été financé à hauteur de 16,5 M€ dans le cadre du projet CPER 2007-2013 Conseil régional d’Ile-de-France pour 10 M€ – Conseil général de l’Essonne à hauteur de 5 M€ et du projet européen “Feder in Europe” porté par la Communauté d’agglomération Seine Essonne.
Fonds européen de développement économique et régional : 1,5 M€













